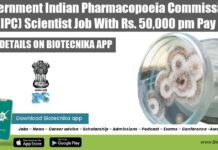
Government Indian Pharmacopoeia Commission (IPC) Scientist Job With Rs. 50,000 pm Pay Pharmacopoeial Scientist Vacancy at IPC

Biotecnika Launches Job Assistance Program (JAP) With Interview Guarantee
Biotecnika Job Assistance Program (JAP) With Interview Guarantee
As we are done with our studies, we are all in a hurry to get onto the...
2023-2024 Fulbright-Kalam Climate Fellowships for Doctoral Research
2023-2024 Fulbright-Kalam Climate Fellowships for Doctoral Research
2023-2024 Fulbright-Kalam Climate Fellowships for Doctoral Research. 2023-2024 Fulbright-Kalam Climate Fellowships Notification. Fulbright-Kalam Climate Fellowships For Indians 2023....
2023-2024 Fulbright-Kalam Postdoctoral Research
2023-2024 Fulbright-Kalam Postdoctoral Research
2023-2024 Fulbright-Kalam Postdoctoral Research. 2023-2024 Fulbright-Kalam Climate Postdoctoral Fellowships Notification. Fulbright-Kalam Climate Fellowships For Indians 2023. Interested and eligible applicants can...
2023-2024 Fulbright-Kalam Academic and Professional Excellence
2023-2024 Fulbright-Kalam Academic and Professional Excellence
2023-2024 Fulbright-Kalam Academic and Professional Excellence. 2023-2024 Fulbright-Kalam Fellowships Notification. Fulbright-Kalam Fellowships For Indians 2023. Interested and eligible applicants...
CMERTI Zoology Research Fellow Recruitment, Applications Invited
CMERTI Zoology Research Fellow Recruitment, Applications Invited
CMERTI Zoology Research Fellow Recruitment, Applications Invited. MSc Zoology/ Sericulture Job Vacant. Interested and eligible applicants can check...
IFF Dairy Designer Job Opening For MSc Food Technology, Apply Online
IFF Dairy Designer Job Opening For MSc Food Technology, Apply Online
IFF Dairy Designer Job Opening For MSc Food Technology, Apply Online. Food technology Designer...
Bose Institute CSIR Funded Research Associate Job Opening
Bose Institute PhD Job - Research Associate Vacancy Available
Bose Institute PhD Job - Research Associate Vacancy Available. PhD Botany / Biochemistry / Microbiology /...
Bhavan’s Research Center (BRC) for Microbiology Recruitment
Bhavan’s Research Center (BRC) for Microbiology R&D Recruitment
About Us
Bhavan’s Research Center (BRC) for Microbiology, established in 2005, has its genesis in the Department of...
India-Taiwan Programme Of Cooperation In Science & Technology 2022
India-Taiwan Programme Of Cooperation In Science & Technology 2022
India-Taiwan Programme Of Cooperation In Science & Technology 2022. R&D Project In Areas Like Biotechnology, Health...
Goa Public Service Commission Designated Officer Recruitment, Apply Online
Goa PSC Designated Officer Recruitment, Apply Online
Goa PSC Designated Officer Recruitment, Apply Online. Goa Public Service Commission Online Recruitment. Goa Public Service Commission Jobs....
Join FREE Webinar on Exclusive RAID Classes For CSIR NET – Do Not Miss...
RAID Concept Classes at Biotecnika - Unique Study Methodology for CSIR NET Life Sciences
Hey guys,
Biotecnika is on a roll and as you all know...
Government Indian Pharmacopoeia Commission (IPC) Scientist Job With Rs. 50,000 pm Pay
Pharmacopoeial Scientist Vacancy at IPC - Indian Pharmacopoeia Commission
Pharmacopoeial Scientist Vacancy at IPC - Indian Pharmacopoeia Commission. Government jobs for MSc & PhD Microbiology/Molecular...
NIBMG Project Associate Recruitment In Human Placenta Project
NIBMG Project Associate Recruitment In Human Placenta Project
NIBMG Project Associate Recruitment In Human Placenta Project. Project Associate-I job. MSc Life Sciences Apply Online. Interested...
Biotecnika Times Newsletter 22.02.2022 – IISc Admissions 2022, GATE 2022 Answer Key
Biotecnika Times - IISc Admissions 2022, GATE 2022 Answer Key
IISc Admission for P. G. / Ph. D. Programmes for the Academic Year 2022-23 -...
NIPER JRF Job For Biotech, Biochem, Microbiology, Life Sciences
NIPER JRF Job For Biotech, Biochem, Microbiology, Life Sciences
NIPER JRF Job For Biotech, Biochem, Microbiology, Life Sciences. National Institute of Pharmaceutical Education & Research,...